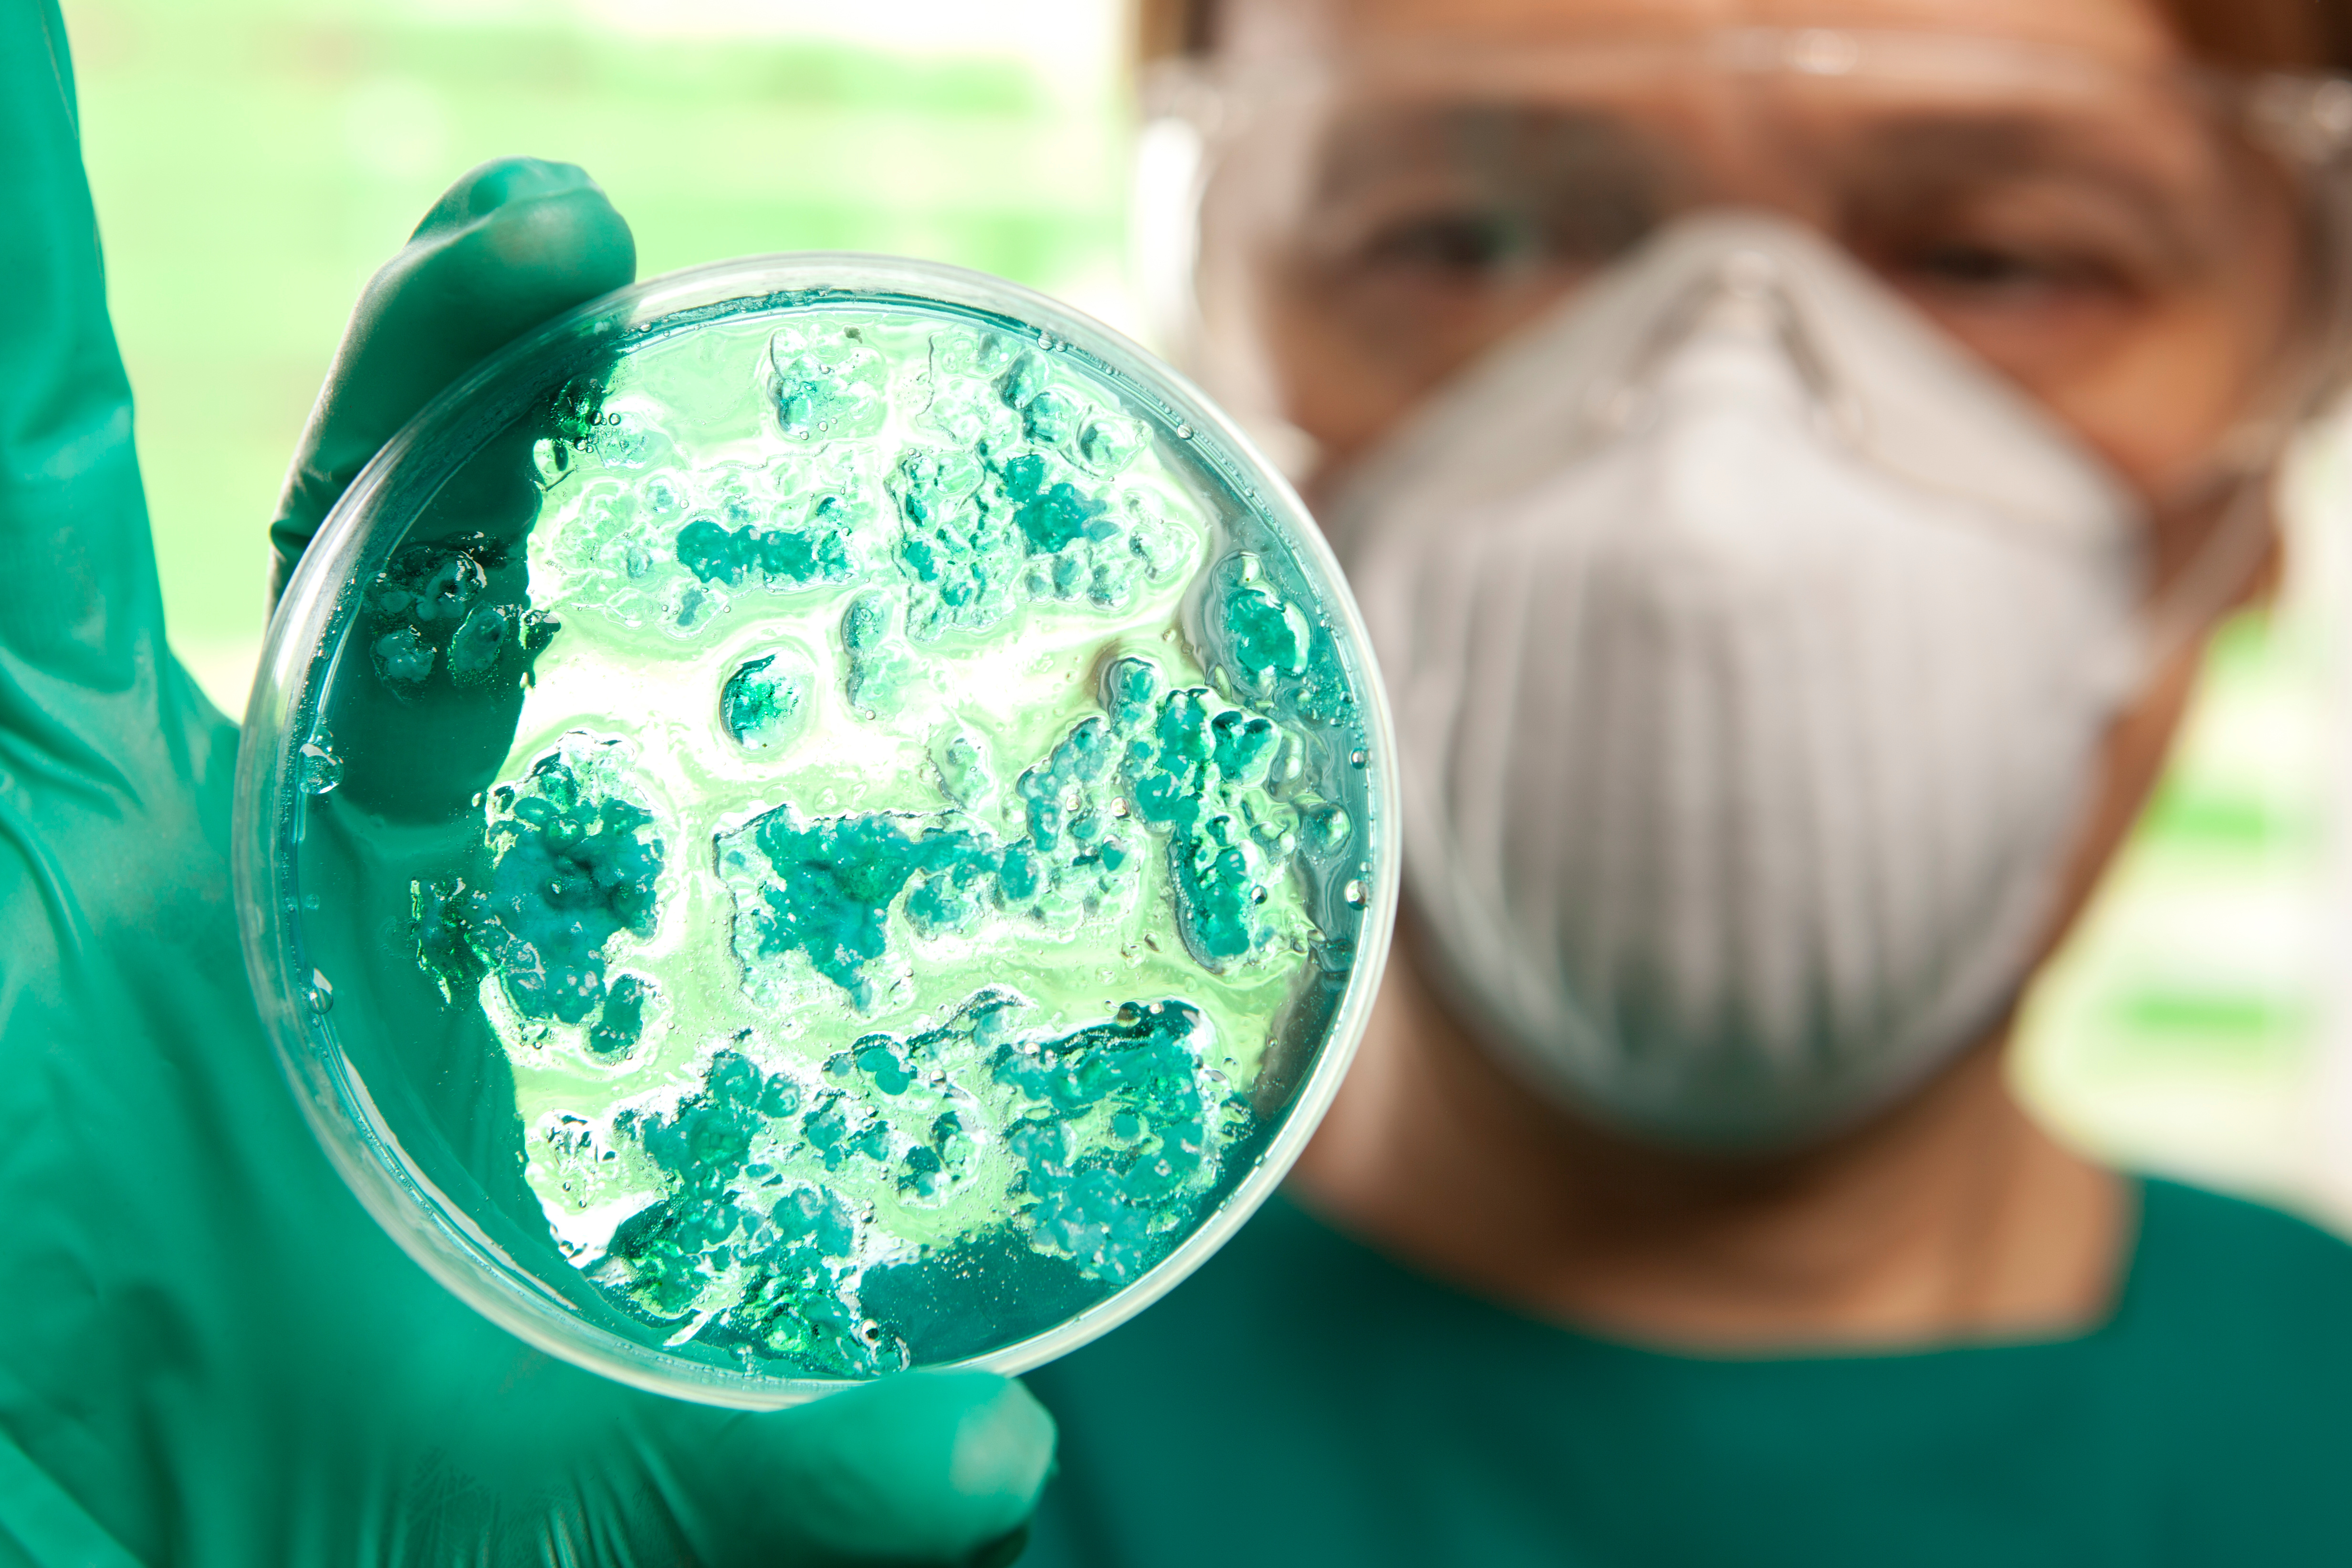
How Africa uses Earth Intelligence to combat infectious disease

Earth Intelligence for All
GEO connects governments, academia, organisations, civil society and the private sector to tackle global challenges through innovative solutions that harness the power of Earth Intelligence.
Our network fosters collaboration and equity, making data and services accessible to enhance sustainable development and environmental management in an era of exponential data growth and planetary-scale crises.
Unlock the Power of Earth Intelligence
Our planet, and the people who depend on it, face environmental challenges that are daunting not only in their quantity, but also in their increasing complexity. This includes climate change, biodiversity loss and pollution, land degradation and environmental disasters. Earth Intelligence can help decision makers plan and monitor interventions that contribute to the transformation of societal structures, policies, practices and mindsets to create harmony with nature.
Earth Intelligence in Action
As global challenges grow, GEO’s mission to protect our planet with Earth intelligence is crucial. Our Strategy emphasizes transformative solutions and intergenerational collaboration.
Read Our StrategyOur Unique Offer
Solutions
GEO leads global initiatives that explore our planet’s ecological health, climate challenges, disaster readiness, resource optimization, urban sustainability, and public health priorities. By integrating Earth Intelligence with global frameworks like the United Nations 2030 Agenda for Sustainable Development, the Paris Agreement, and the Sendai Framework for Disaster Risk Reduction, GEO demonstrates its commitment to fostering a healthy, sustainable, and resilient world.

Agriculture and Food Security
Agriculture and Food Security represents the crucial link between sustainable agriculture and global food security, aiming to boost agricultural productivity, stabilise food supplies and reduce malnutrition.
Discover SolutionDriving Progress Together
Our collaborators harness the convening power of GEO to forge partnerships to create solutions with Earth Intelligence. We welcome opportunities to establish new relationships with governments, organisations, academia, civil society, the private sector and the public to harness the power of Earth Intelligence.
.png)

